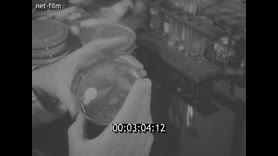
Footage frame

Footage Research by British scientists in the field of pharmacology. (1944)

Scene 1
0:07:40Research by British scientists in the field of pharmacology (1944)
Scene №1 Research by British scientists in the field of pharmacology

A wounded and infected British soldier being transported to a hospital in Holland in November 1944. Orderlies remove a stretcher with a patient from an ambulance.
A patient is carried on a stretcher into the hospital barracks.
A orderly cuts a soldier's trousers with scissors.
A view of a damaged windmill as an ambulance passes by.
An officer on the side of the road points the ambulance in the direction of the stretcher.
British soldiers remove a stretcher with a patient from an ambulance van.
Orderlies carry the stretcher into the hospital building.
Blood plasma is administered to the patient through an IV. The face of a recovered patient.
A container with blood plasma.
Orderlies carry a stretcher to a van.
The ambulance drives down the street past destroyed buildings.
The patient's face.
Doctors performing surgery, the patient's face.
Disinfection of the wound edges with a special sprayer.
A orderly prepares a penicillin IV. The patient on the bed.
The process of intravenous administration of penicillin through a drip.
The patient's face.
An orderly makes a note about the penicillin administration on the patient's personal card.
The face of a scientist conducting an experiment to obtain penicillin.
A scientist in a laboratory examines and studies samples of the obtained penicillin.
Penicillin under a microscope.
A scientist at work, the scientist's face in profile (close-up).
A scientist records the results of the study.
The entrance to the William Dunn School of Pathology building in Oxford.
The face of Professor Howard Walter Florey, one of the developers of penicillin.
Dr.
Ernst Chain conducts an experiment in the laboratory of the School of Pathology in 1944. A scientist from the penicillin development group keeps track of samples of the drug grown in laboratory vessels.
Conducting an experiment to create penicillin in the laboratory of the School of Pathology.
Norman Heatley compares samples of the obtained penicillin.
The process of isolating penicillin.
Conducting laboratory experiments with staphylococci.
Biochemist Edward Abraham conducts another experiment.
A lab technician's face.
Staphylococci under a microscope.
Professor Florey conducts a laboratory experiment on mice.
White mice during the experiment.
A syringe with a penicillin injection on the palm.
The experiment on white mice continues, Professor Florey observes the experiment.
Doctors administer a test injection of penicillin to an elderly patient.
The doctor examines the patient.
The scientist records the results of the study.
Inspection of laboratory equipment for producing penicillin on an industrial scale.
Persons:
Flory Howard Walter - Australian and English pharmacologist
Ernst Boris Chain, British biochemist
Abraham Edward Penley -- British biochemist
Calendar:
1944
Shooting locations:
Netherlands, England
Seasons:
Autumn